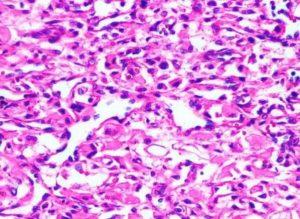
母细胞瘤病因-症状-能活多久

11
7月
胃癌遗传吗?如何预防?诊断和治疗方法有哪些?能活多久?有哪些注意事项?
胃癌是一种恶性肿瘤,起源于胃黏膜上皮细胞。在我国,胃癌是最常见的恶性肿瘤之一,占据胃部恶性肿瘤的95%以上,约占全部癌症发病的11%左右。男性的胃癌发病率约为十万分之五十四左右,女性发病率约为十万分之二十三左右,胃癌在消化系统肿瘤中排名第一,全身恶性肿瘤发病率排名第三。 以下是关于胃癌发病情况的详细信息: 发病率:胃癌的发病率在不同国家和地区存在较大差异。在东亚国家如日本、中国等地,胃癌的发病率较高,约有三分之二的病例分布在发展中国家。在中国国内,北方地区的发病率高于南方,农村的发病率高于城市,男性的发病率和死亡率均高于女性。 死亡率:全国平均年死亡率约为每十万人中有16人死于胃癌,男性为21... 查看详情
10
7月
全面了解肺癌的特点、类型、病因、症状、诊断、治疗和预防
肺癌在全球范围内具有极高的发病率和死亡率,并且呈上升趋势。根据2018年的统计数据,男性肺癌发病率和死亡率均居恶性肿瘤的第一位。在女性中,肺癌的发病率排名第三,死亡率仅次于乳腺癌,位居第二位。 根据中国2015年的统计数据,肺癌在中国男性和女性中分别是恶性肿瘤发病率的第一和第二位,并且在死亡率方面也居首位。近年来,肺鳞癌的发病率有所下降,约占肺癌的30%~40%;而腺癌的发病率呈上升趋势,约占肺癌的40%~55%。 什么是肺癌 肺癌是一种恶性肿瘤,它起源于肺组织中的异常细胞。肺是人体呼吸系统的一部分,其主要功能是吸入氧气并排出二氧化碳。然而,当正常的肺细胞经历基因突变或异常增殖时,它们可以形成... 查看详情
10
7月
肾癌的早期症状和征兆,能治好吗,存活率多少,如何护理
肾癌在泌尿系统肿瘤中排名第三,仅次于前列腺癌和膀胱癌。全球范围内,肾癌的发病率约占成年人恶性肿瘤的3%。肾癌的分布存在明显的地域差异,西方发达国家如北美和西欧的发病率较高,而非洲和亚洲等发展中国家的发病率相对较低。 根据2012年的全球恶性肿瘤流行病学研究数据,肾癌在全球恶性肿瘤中的发病率排名第14位,死亡率排名第16位。近几十年来,肾癌的发病率在大多数国家和地区都呈现持续增长的趋势,包括北美、部分欧洲、亚洲、大洋洲和部分拉丁美洲。然而,在发达国家中,肾癌的死亡率趋于稳定或下降。 根据中国肿瘤登记年报的数据,从1998年到2014年,我国肾癌的发病率呈上升趋势。这可能是由于人口结构老龄化、生活... 查看详情
09
7月
肝癌会传染和遗传吗?如何治疗?能活多久?肝癌患者应注意哪些?
肝癌是我国最常见的恶性肿瘤之一。根据国家癌症中心发布的2015年我国恶性肿瘤数据,肝癌在新发病例中达到37万例,位居恶性肿瘤第4位。同时,肝癌在死亡病例中也非常高,达到32.6万例,位居恶性肿瘤第2位。 肝癌在人群中有一定的性别和年龄差异。肝癌好发于中年男性,男女患病比例约为3.5:1。在2015年的统计数据中,肝癌的发病率在男性中位居第3位,在女性中位居第7位。而肝癌的死亡率在男性中排名第2位,在女性中排名第3位。 肝癌的类型 肝癌可分为原发性肝癌和继发性肝癌两大类。原发性肝癌主要包括肝细胞癌、肝内胆管癌和混合型肝癌,其中肝细胞癌占到85%——90%以上的比例。与原发性肝癌相比,继发性肝癌更... 查看详情
08
7月
结直肠癌的早期症状和诊断,如何治疗和预防?
什么是结直肠癌 结直肠癌,又被称为大肠癌,是一种源自大肠上皮的恶性肿瘤,包括结肠癌和直肠癌。其中,腺癌是最常见的病理类型,只有极少数是鳞癌。在我国,直肠癌是最常见的类型,其次是结肠癌(包括乙状结肠、盲肠、升结肠、降结肠和横结肠)。 结直肠癌的发病情况 结直肠癌是全球范围内第三最常见的恶性肿瘤,也是第二最常见的致命恶性肿瘤。根据世界卫生组织癌症研究中心(WHO)的GLOBOCAN项目估计,2018年全球新发结直肠癌病例约为180万,死亡人数约为88万。 发病因素: 结直肠癌的发病与年龄、地区和性别等因素有关: 年龄:结直肠癌主要发生在40岁以上的中老年人。 性别:结肠癌的男女发病率相近,而直肠癌... 查看详情
07
7月
纤维瘤会癌变吗?纤维瘤的病因、诊断以及如何治疗?
纤维瘤是来源于纤维结缔组织的良性肿瘤,发病率为软组织良性肿瘤的1.37%。多发于40~50岁成人,儿童和青少年也不少见。发病原因尚不清楚,可能与外伤、激素和遗传因素有关。瘤组织内的胶原纤维排成束状,互相编织,纤维间含有细长的纤维细胞;外观呈结节状,与周围组织分界明显,有包膜;切面灰白色,可见编织状的条纹,质地韧硬;常见于四肢及躯干的皮下。本病发病年龄多在40~50岁成人,儿童和青少年也不少见。肿瘤可发生在身体任何部位的大肌肉,以腹壁的腹直肌及其邻近肌肉的腱膜最为常见,好发于妊娠期和妊娠后期。若为腹壁外者,则多见于男性,好发于肩胛部、股部和臀部。 纤维瘤的类型 纤维瘤,根据其组织成分的不同,可分... 查看详情
07
7月
白血病的症状表现与征兆、检查与诊断、治疗措施与预防
我国白血病的患病率约为3~5/10万。2015年,全国新发白血病患者约为7.53万人。白血病在致死率排名中位于恶性肿瘤的第6位(男性)和第7位(女性),而在儿童和35岁以下的成人中居首位。2015年,全国因白血病死亡的患者约有53.4万人。 在我国,急性白血病的发病率高于慢性白血病。其中,急性髓系白血病最为常见,其次是急性淋巴细胞白血病(约占15%)和慢性髓系白血病(约占15%)。成人多见急性髓系白血病,而儿童多见急性淋巴细胞白血病。随着年龄增长,急性和慢性髓系白血病的发病率逐渐上升。 什么是白血病 白血病是一种恶性克隆性疾病,起源于造血干细胞,导致白血病细胞在细胞发育过程中失去正常控制,从而... 查看详情
06
7月
甲状腺癌的类型、分期、症状、诊断、治疗及预期寿命
全球范围内,甲状腺癌的发病率近年来呈迅速增长的趋势。据全国肿瘤数据登记中心的测算,我国甲状腺癌每年以惊人的20%的速度持续增加。截至2013年,我国约有14.39万人被诊断患有甲状腺癌,相当于每10万人中大约有10人患上这种疾病。而女性的发病率明显高于男性。 甲状腺癌分为四种类型 甲状腺癌可根据肿瘤起源和分化程度进行分类,主要包括以下类型: 甲状腺乳头状癌(PTC):这是最常见的甲状腺癌类型,约占所有甲状腺癌的85%~90%。它具有明显的分化特点。 甲状腺滤泡癌(FTC):占甲状腺癌的一部分,分化程度较高。 甲状腺髓样癌(MTC):这种类型的癌症源自甲状腺的C细胞,其恶性程度介于分化型甲状腺癌... 查看详情
06
7月
淋巴瘤好治吗?早期和晚期都有哪些症状?如何治疗和护理?
淋巴瘤是一种恶性肿瘤,源自于淋巴结和淋巴组织,可以在人体的任何部位发生,其临床表现多种多样。 这种疾病通常以进行性淋巴结肿大为特征,而且往往是无痛的。此外,淋巴瘤还可以侵犯鼻咽部、胃肠道、骨骼和皮肤等结外器官,造成相应器官的受损,并常常伴有发热、消瘦、盗汗等全身症状。 那么淋巴瘤在不同人群中的发病情况如何呢?目前的数据显示,淋巴瘤的发病率逐年增加。根据世界卫生组织(WHO)的估计,2018年全球新发淋巴瘤病例约为58.96万例(其中霍奇金淋巴瘤约为8.00万例,非霍奇金淋巴瘤约为50.96万例),全球标化发病率为每10万人中约有6.6例。具体来看: 美国的新发病例数约为8.26万例(其中霍奇金... 查看详情
06
7月
母细胞瘤是什么,病因和症状是怎样的,能治好吗?
母细胞瘤是一种恶性肿瘤,起源于神经外胚层组织中的母细胞(也称为神经嵴细胞)。它通常发生在婴幼儿和幼儿身上,但在罕见情况下也可发生于成年人。母细胞瘤可以发生在各个部位,最常见的部位是儿童的头部和颈部区域。 母细胞瘤是一种怎样的病 母细胞瘤是一种未分化的原始细胞疾病,母细胞瘤并不是一个确定的疾病名称,而是一个泛指的术语,它指的是一类肿瘤,起源于母细胞(未成熟的原始细胞),具有多种细胞分化潜能。这些细胞可以发展成不同类型的细胞,包括神经母细胞瘤、胶质母细胞瘤、骨母细胞瘤等。 1、神经母细胞瘤:这是一种神经内分泌性肿瘤,在婴儿期时常见于颅外实体肿瘤之中。该疾病非常恶性,通常发生在肾上腺或其他部位,主要... 查看详情